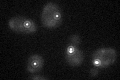
YKL042W

View description
Central plaque component of spindle pole body (SPB); involved in SPB duplication, may facilitate attachment of the SPB to the nuclear membrane
Localization:
Intensity:
Fold change:
Significance:
-
C’ GFP library in SD

punctate30.21 -
N' NOP1pr-GFP in SD

punctate132.723 -
N' TEF2pr-mCherry in SD

missing0 -
N' NATIVEpr-GFP in SD

punctate43.6444 -
N' TEF2pr-VC and Cyto-VN in SD

#N/A0 -
C’ GFP library in SD+DTT

punctate25.410.84No -
C’ GFP library in SD+H2O2
punctate28.490.94No -
C’ GFP library in Starvation Media

punctate45.161.49Yes -
C’ GFP library on the background of Pup2-DaMP

punctate -
C’ GFP library on the background of CCT mutant

punctate25.53670.845178No
